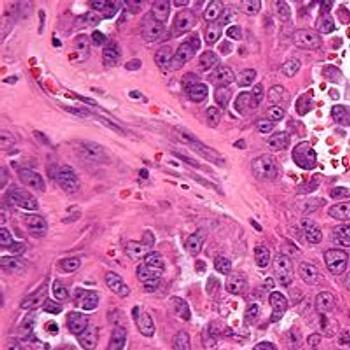

Scientific Interchange & Workshop
Advertisement
Advertisement
Trending on OncLive
1
Long-Term Cilta-Cel Data Show Low Rates of PFS Events in Standard-Risk R/R Myeloma
2
Real-World Data Support Clinical Benefit With Lifileucel in Previously Treated Advanced Melanoma
3
FDA Updates Axi-Cel Label to Remove Limitation of Use in R/R PCNSL
4
Dr Riedell on the Long-Term Efficacy of Tisa-Cel in R/R Follicular Lymphoma
5